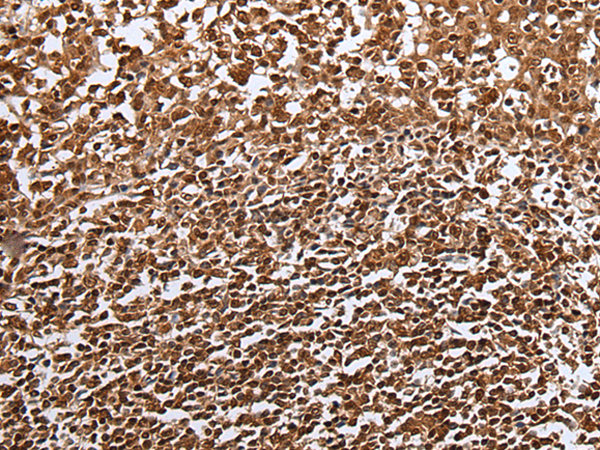

|
Background: |
The protein encoded by this gene has substantial phospholipase activity and may be involved in lipoprotein metabolism and vascular biology. This protein is designated a member of the TG lipase family by its sequence and characteristic lid region which provides substrate specificity for enzymes of the TG lipase family. |
|
Applications: |
ELISA, IHC |
|
Name of antibody: |
LIPG |
|
Immunogen: |
Fusion protein of human LIPG |
|
Full name: |
lipase, endothelial |
|
Synonyms: |
EL; EDL; PRO719 |
|
SwissProt: |
Q9Y5X9 |
|
ELISA Recommended dilution: |
5000-10000 |
|
IHC positive control: |
Human esophagus cancer and human breast cancer |
|
IHC Recommend dilution: |
40-250 |

購(gòu)物車
幫助
021-54845833/15800441009
